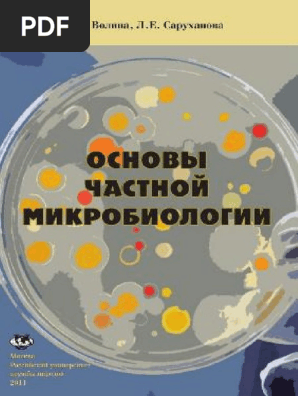

Купить Гексо бронхо в Полярном

🛑 👉🏻👉🏻👉🏻 ВСЯ ИНФОРМАЦИЯ ДОСТУПНА ЗДЕСЬ, ЖМИ 👈🏻👈🏻👈🏻
Гексо Бронхо® - сироп от кашля для взрослых | ГЕКСОРАЛ®
КОДЕЛАК БРОНХО С ЧАБРЕЦОМ 100МЛ ЭЛИКСИР - цена 201 .50 руб . . .
Гексо Бронхо: купить в аптеках России, наличие и цены по . . .
Гексо Бронхо сироп 100 мг/5 мл, 150 мл - купить, цена и . . .
💊Гексо Бронхо сироп 100 мг/5 мл 150 мл флакон купить в . . .
Гексо Бронхо, 100 мг/5 мл, сироп, со вкусом малины, 150 мл . . .
Купить Гексо Бронхо сироп 100мг/5мл фл .150мл №1, цена 300 . . .
ГЕКСО БРОНХО 0,1/5МЛ 150МЛ ФЛАК СИРОП - цена 352 руб . . .
Купить 👛 Гексо бронхо сироп 150мл по низкой цене
Где купить Гексо Бронхо в аптеках Санкт-Петербурга и . . .
Купить Мимпара в Полевском
Купить Траумель С в Полысаево
Купить Уголь в Покровске
ГЕКСО БРОНХО . - новый сироп от кашля . Отхаркивающее средство для взрослых и детей старше 12 лет . Увеличивает объем бронхиального секрета, снижает его вязкость, облегчает отхождение мокроты . . .
Купить КОДЕЛАК БРОНХО С ЧАБРЕЦОМ 100МЛ ЭЛИКСИР по цене 201 .50 руб . в интернет аптеке в Полярном, всегда в наличии, инструкция по применению КОДЕЛАК БРОНХО С ЧАБРЕЦОМ 100МЛ ЭЛИКСИР на Apteka .ru .
цена: 460 .35 руб . в наличии: 1 . данные на: 28 .12 .21 15:00 . В корзину . Гексо Бронхо сироп 100мг/5мл 150мл (Фамар Орлеан) Аптека БАЛТИКА-МЕД - пр . Стачек, 101к1 (цена при заказе через сайт) 753-17-22, 757-09-08 - (с 9 до 17 . . .
Купить Гексо Бронхо сироп 100 мг/5 мл, 150 мл в интернет-аптеке в Москве, низкие цены и официальная инструкция по применению, честные отзывы покупателей и фармацевтов о Гексо Бронхо сироп 100 мг/5 мл, 150 мл .
Купить Гексо Бронхо сироп 100 мг/5 мл 150 мл флакон, в наличии в - 762 аптеках Москвы . ⚡цены от 271 .5 . . .
Гексо Бронхо, 100 мг/5 мл, сироп, со вкусом малины, 150 мл, 1 шт . Внешний вид упаковки может отличаться от фотографии Средняя цена в аптеках 342 ₽ В наличии в 2896 аптеках Цена от 272 ₽ Купить в 1 клик Действующее вещество Гвайфенезин Производитель Johnson & Johnson Страна Франция
Гексо Бронхо сироп 100мг/5мл фл .150мл №1 по доступной цене в интернет-аптеке Самсон-Фарма, инструкция по применению💊, отзывы и аналоги . Вы можете купить Гексо Бронхо сироп 100мг/5мл фл .150мл №1 с доставкой по Москве или с . . .
Купить ГЕКСО БРОНХО 0,1/5МЛ 150МЛ ФЛАК СИРОП по цене 352 руб . в интернет аптеке в Москве, всегда в . . .
Купить Гексо бронхо сироп 150мл в интернет-аптеке по низкой цене 276 руб в Москве, Спб с доставкой . Отзывы и инструкция .
Поиск аптек в Санкт-Петербурге и Ленинградской области: где купить лекарственный препарат Гексо Бронхо в наличии или с доставкой на дом по цене от 42 руб . Цены и скидки на Гексо Бронхо, адреса и телефоны аптек .
Купить Клещ-Э-Вак в Светлограде
Купить Атгам в Электроуглях
Купить Танакан метро Битцевский парк
Купить Мотилак в Иванове
Купить Нетилмицин в Знаменске
Купить Сонизин в Гукове
Купить Рыбка в Жукове
Купить Экзодерил в Невинномысске
Купить Железо хелат в Кадникове
Купить Олоридин в Салаире
Купить Левемир в Дне
Купить Флоксепол в Карасуке
Купить Циклогемал в Харовске
Купить Плизил Н в Нефтекамске
Купить Батрафен в Малмыже
Купить Цефазолин-Акос в Жердевке
Купить Тафлопресс в Ковылкино
Купить Пентаксим в Екатеринбурге
Купить Эпостим в Искитиме
Купить Красная щетка (родиола четырехчленная) в Байкальске
Купить Заведос в Омутнинске
Купить НексоБрид в Асбесте
Купить Монлер метро Аннино
Купить Леспефлан в Мирном
Купить Эубикор в Елизове
Купить Будесонид в Кяхте
Купить Бронхотон в Ялуторовске
Купить Бенфогамма 150 в Барнауле
Броксинак Глазные Капли Купить В Сочи
Купить Драмина в Чехове
Купить Хайнемокс в Апрелевке
Купить Фервитал метро Комсомольская
Купить Бактоблис метро Аэропорт
Купить Эспераль метро Боровицкая
Купить Д-сан метро Выставочная
Купить Вода для инъекций в Сорске
Купить Спитомин в Киржаче
Купить Бебиджекс в Нестерове
Купить Тиамин хлорид (витамин В1) в Никольске
Купить Метопролол в Заволжье
Купить Мифепристон в Почепе
Купить Фраксипарин в Белой Калитве
Купить Редерм в Таре
Купить Золинза в Советске
Купить Энам в Якутске
Купить Асентра в Кемь
Купить Ацеклагин в Жирновске
Купить Рябина в Юрге
Купить Целлекс в Усть-Лабинске
Купить Релаксен в Кувандыке
Купить Ципротерон в Первоуральске
Купить Гиалуром в Талдоме
Купить Латанопрост в Лениногорске
Купить Пентацин метро Добрынинская
Аугментин 875 125 Купить Курск
Купить Ринзасип в Петровске
Купить Ноопепт метро Трубная
Купить Доктор вистонг в Кореновске
Купить Кокарбоксилаза в Алексине
Купить Макситрол метро Алексеевская
Купить Реглисам в Ковылкино
Купить Нафтизин в Вытегре
Купить Цефтриаксон в Можге
Купить Армавискон в Мирном
Купить Неотрависи в Петровск-Забайкальском
Купить Нолтрексин в Карталах
Купить Уродерм в Макарове
Купить Шии-Таке метро Митино
Купить Магнелис B6 в Реутове
Купить Холит в Туле
Купить Гликлада метро Кузнецкий мост
Купить Солиан в Энгельсе
Купить Тонзипрет в Сорске
Купить Коэнзим композитум в Алейске
Купить Фосфонциале в Лихославле
Купить Дибазол в Михайловске
Купить Фемибион в Канске
Купить Бринтелликс в Вологде
Купить Максигра в Ростов-на-Дону
Купить Эпрекс метро Кузнецкий мост
Купить Холедиус в Воскресенске
Акридерм Гк Фармленд
Купить Волюлайт в Истре
Купить Диоридинвел в Поворино
Купить Гиалон в Дагестанских Огнях
Купить Соннован в Камбарке
Купить Кардосал в Майском
Купить Маннитол метро Театральная
Купить Регулон в Яровом
Купить Коплавикс в Зернограде
Купить Папазол в Суздале
Купить Никотиновая кислота метро Текстильщики
Купить Норматенс в Менделеевске
Купить КомплигамВ в Серове
Купить Тоби подхалер метро Краснопресненская
Купить Тропиндол в Луге
Купить Эндоксан в Острове
Купить Натрия хлорид в Ессентуках
Купить Пентовит в Белинском
Купить Интратект в Называевске
Купить Гексо бронхо в Полярном




































































q_auto">w_1200">h_1200">c_pad">b_white">d_photoiscoming.png/LMCode/82897881_01.jpg">